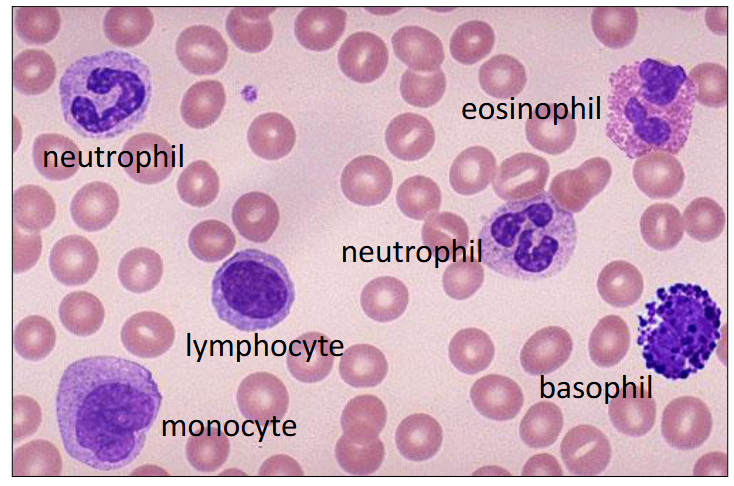
<p>- Leuco = white</p><p>- Cyte = cells</p><p>.</p><p>- the colours are as seen in a blood smear after Romanovsky staining</p>
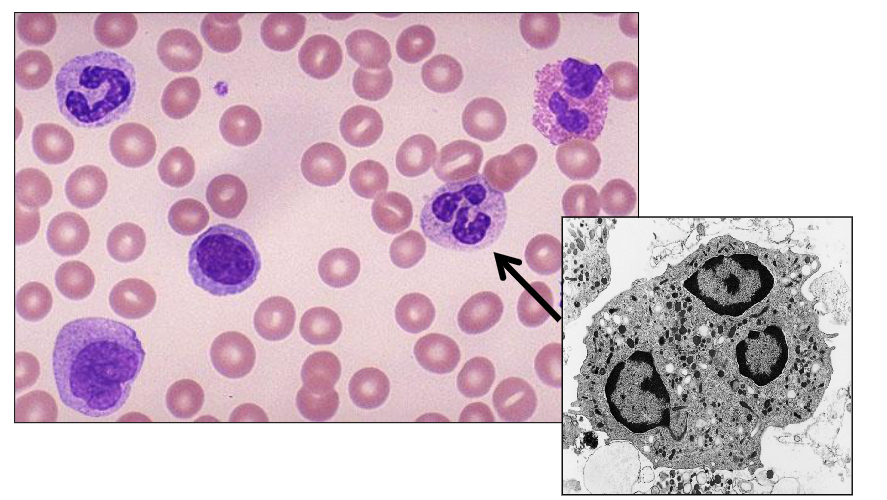
<p>DIAGRAM ON SLIDE 8</p>
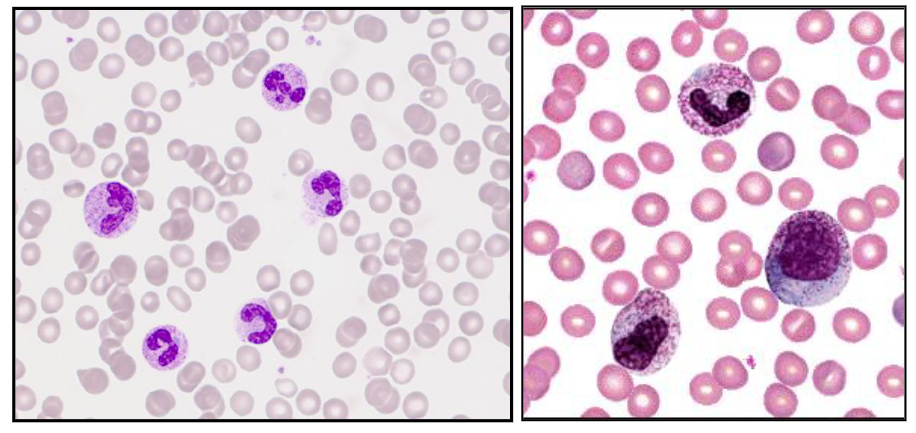
<p>- Increase in neutrophils with left shift and increased granulation</p><p>- secondary to infection, inflammation, tissue damage, drugs, cytokines</p><p>.</p><p>- A neutrophil left shift signifies an increased number of immature neutrophils (such as band cells) in the bloodstream, indicating the bone marrow is releasing them early to fight acute infection, severe inflammation, or marrow stress. It is a marker of intense, often bacterial, inflammation. (its as if we took the diagram above and turned it so that myeloblasts were on the left)</p><p>.</p><p>- image on the right shows significant left shift</p>
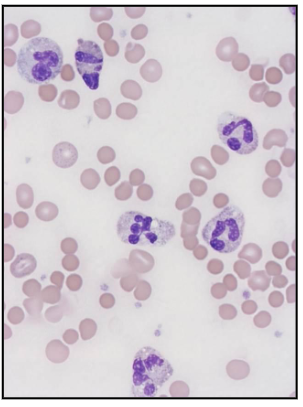
<p>- Symptoms: fever, lethargy</p><p>- Acute, chronic infections</p><p>- Localised: e.g. skin, tonsil, bone</p><p>.</p><p>Generalised:</p><p>- Low blood pressure (hypotension)</p><p>- Can lead to organ failure</p><p>.</p><p>Haematological response:</p><p>- Bone marrow granulocytic hyperplasia</p><p>- Neutrophilia, left shift, toxic granulation, Döhle bodies</p><p>.</p><p>- Staphylococcus, Streptococcus, Neisseria etc</p>
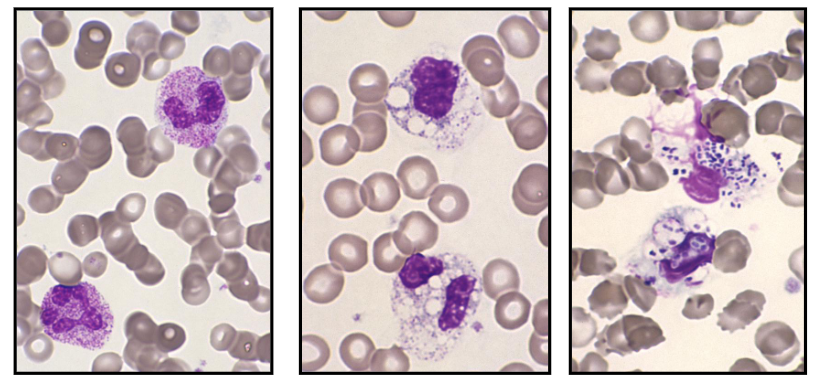
<p>Neutrophillia with Toxic Granulation</p>
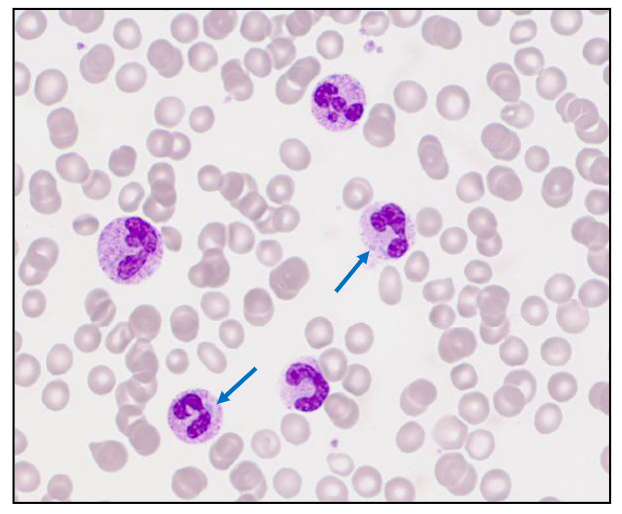
<p>- Basophillic neutrophil cytoplasmic inclusions</p><p>- Evidence of long-standing severe bacterial sepsis</p>
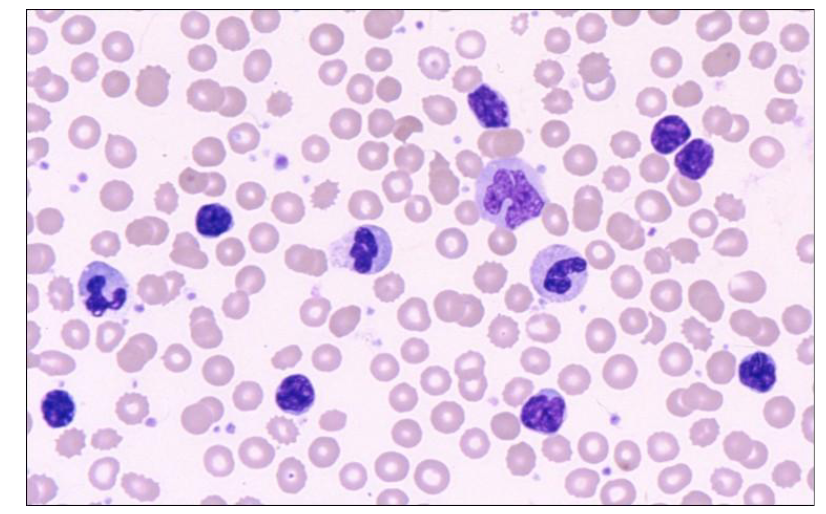
<p>Which of the cells in this image are neutrophils</p>
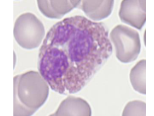
<p>Eosinophils</p>
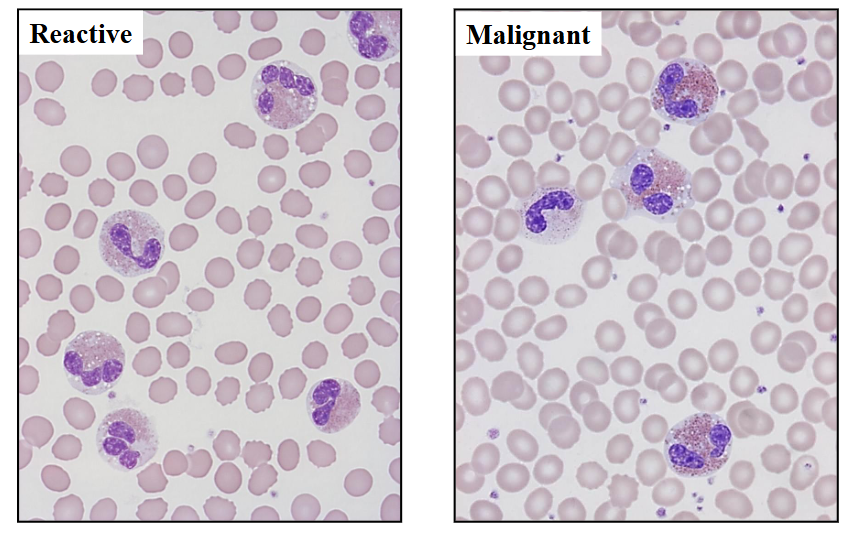
<p>Eosinophillia</p>
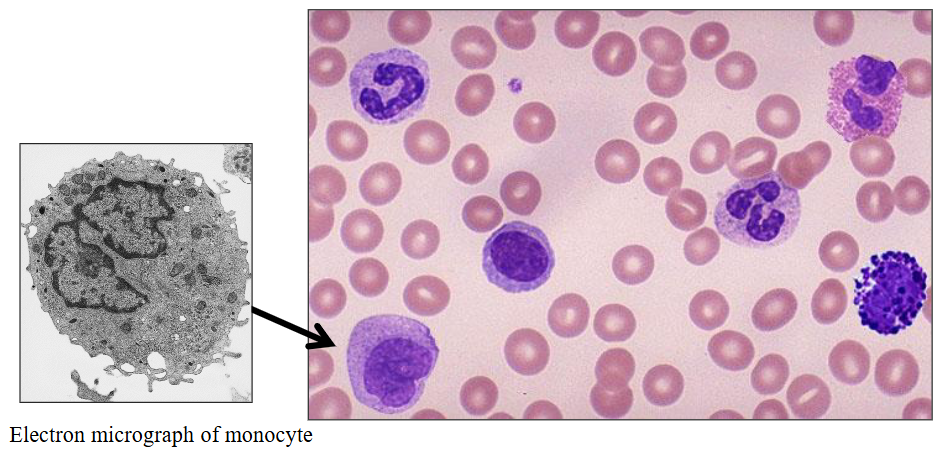
<p>DIAGRAM ON SLIDE 33</p>
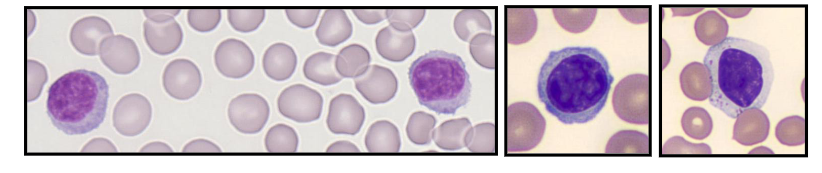
<p>- Immunologically competent cells</p><p>- Produced in bone marrow and thymus</p><p>- BM: 10-15% of BM cells; T : B ratio = 6:1</p><p>- 20 - 45% of white cells (= 1.5 - 4 x109/L)</p><p>- PB: T (70-85%) and B (5-25%) lymphocytes</p><p>- Round cells with mature chromatin</p><p>- Some are larger and have cytoplasmic granules</p>
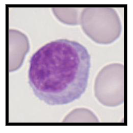
<p>- Age-dependent reference ranges</p><p>- Average life span 4 years (up to 10 years)</p><p>.</p><p>Two major functionally distinct groups, B- and T-cells</p><p>- PB: T (70-85%) and B (5-25%) lymphocytes</p><p>- Also natural killer cells (large granular lymphocytes <5%)</p><p>.</p><p>- T cells: Cell mediated immunity</p><p>.</p><p>B cells:</p><p>- Produce immunoglobulins (groups of proteins)</p><p>- Further development of B lymphocytes in lymph nodes</p>
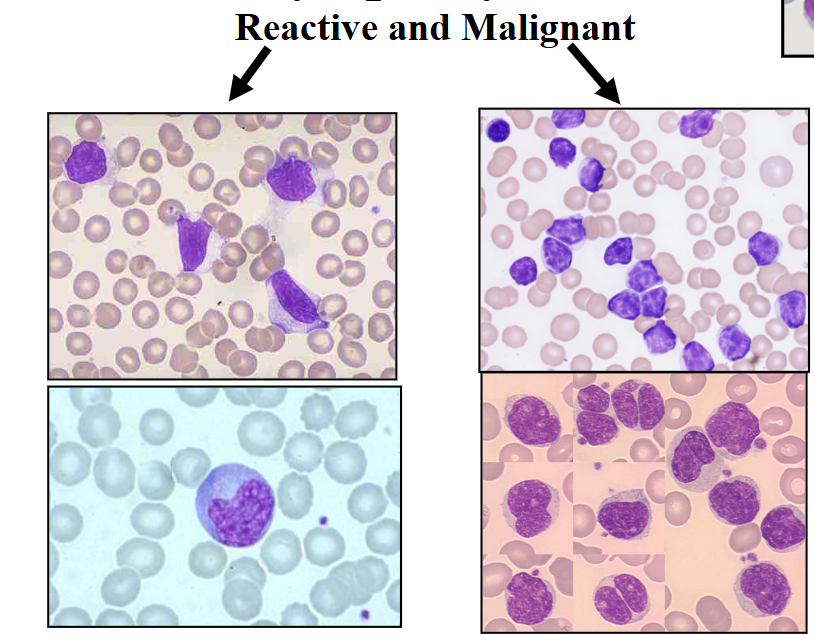
<p>Lymphocytosis (Reactive vs Malignant)</p>
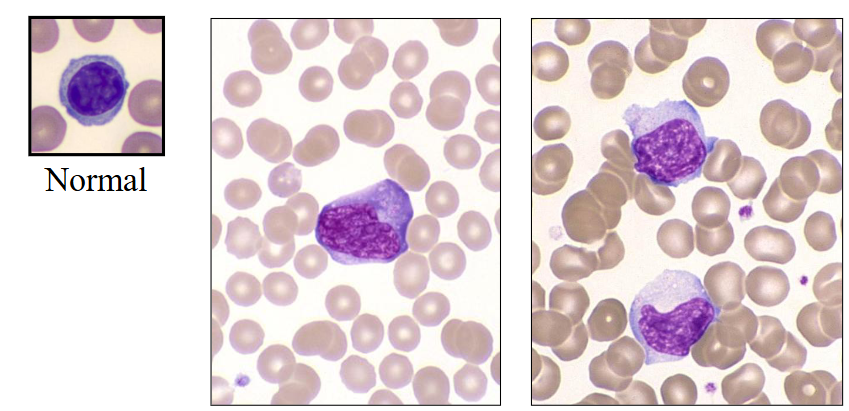
<p>- large activated lymphocytes with irregularly shaped nuclei; abundant flowing basophilic cytoplasm with a dark-staining periphery</p>

1/53
Looks like no tags are added yet.
Name | Mastery | Learn | Test | Matching | Spaced | Call with Kai |
|---|
No analytics yet
Send a link to your students to track their progress

Leucocytes in the Blood
- Leuco = white
- Cyte = cells
.
- the colours are as seen in a blood smear after Romanovsky staining

1. Haemopoiesis
DIAGRAM ON SLIDE 4


Granulopoiesis
DIAGRAM ON SLIDE 5


Granulopoiesis in the BM
- early precursors adjacent to bony trabeculae
- Maturing forms deeper in marrow space


Granulopoiesis explanation
- HSCs undergo specific differentiation in response to cytokines with orderly sequence of maturation
- Nuclear maturation and cytoplasmic granulation


a) Neutrophils
DIAGRAM ON SLIDE 8

Neutrophils
- 40 - 75% of WBC (absolute count = 2.5 - 7.5 x109/L)
- Develop from primitive myeloblast in BM
- Myeloblast
- Promyelocyte
- Myelocyte
- Metamyelocyte
- Band form
- Neutrophil
.
- exam wont ask you to remember the intermediate stages and names of the cells, but you do need to remember the process goin from primitive blast through to the mature neutrophil, takes about 7 days and derived from CD34+ haematopoietic stem cell under the influence of GCSF


Neutrophil Maturation
- Reduction in size during differentiation
.
Contain fine granules (azurophilic)
- Primary and secondary (specific) cytoplasmic
- Contain enzymes involved in "killing"
.
- Neutrophil nucleus segments (2 -5 segments); females have drumstick-like appendage (20%)
- Neutrophil migrates to tissue
- 9-15 micrometre diameter
- Phagocytic function
.
- dont stay in the blood for too long, they have transient function because their role is to phagocytose and remove invading pathogens and organisms

Number and Life Span
Number in blood varies by:
- Age, gender, ethnicity
- Caucasians, Chinese, Indians: comparable
- Ethnic neutropenia (African; Arab descent)
.
Mature neutrophil migrates from BM to blood
- Migrates through the sinusoidal endothelium
- Lifespan in PB (peripheral blood): t1/2 of 2.5 - 12 hours (mean 7 hrs)
- Appear in secretions and tissues
- Survive outside the blood for up to 30 hours
.
- they use the bloodstream as a transport system to get from bone marrow to where they need to go to undergo their activity in body tissues and secretions
- even when they're in the tissues they're not there for very long, very short lifespan
- ethnic neutropenia means that they are making normal neutrophil levels but because they get marginated on vessel wall it appears neutropenic. So we have to decide if we have ethnic neutropenia or a real disorder (neutropenia)

Age and Leucocyte Counts
number of neutrophils is highest 24h after birth
- then it settles to normal levels after that for rest of life


How do Neutrophils work
- Attracted to and move to sites of infections
- Adhere to the foreign particle via receptors
- Pseudopodia form and encircle the particles
- Ingest foreign particles
- Phagosome forms
- Fusion of primary & secondary granules
- Granule contents discharged
- Bacterial kill
.
- Primary (azurophilic) granules are formed early, containing digestive enzymes (myeloperoxidase, elastase), while secondary (specific) granules form later, releasing regulatory proteins (lactoferrin) to fight pathogens

Neutrophillia (increased neutrophil count)
Reactive neutrophilia:
- 10 - 50 x 10^9/L
- Increased granulation"toxic"
- Döhle bodies
- Cytoplasmic vacuoles
- "Left shift"
.
Causes:
Infection
- Bacterial
- (Viral)
Other causes include:
- Acute inflammation
- Stress, exertion
- Pregnancy
- Surgery, trauma, tissue damage or infarction
- Steroids, cytokines

Reactive Neutrophillia
- Increase in neutrophils with left shift and increased granulation
- secondary to infection, inflammation, tissue damage, drugs, cytokines
.
- A neutrophil left shift signifies an increased number of immature neutrophils (such as band cells) in the bloodstream, indicating the bone marrow is releasing them early to fight acute infection, severe inflammation, or marrow stress. It is a marker of intense, often bacterial, inflammation. (its as if we took the diagram above and turned it so that myeloblasts were on the left)
.
- image on the right shows significant left shift

Bacterial Infections
- Symptoms: fever, lethargy
- Acute, chronic infections
- Localised: e.g. skin, tonsil, bone
.
Generalised:
- Low blood pressure (hypotension)
- Can lead to organ failure
.
Haematological response:
- Bone marrow granulocytic hyperplasia
- Neutrophilia, left shift, toxic granulation, Döhle bodies
.
- Staphylococcus, Streptococcus, Neisseria etc

Dohle body
- Döhle bodies are light blue-gray, oval-shaped inclusions found in the cytoplasm of neutrophils and band cells, representing remnants of rough endoplasmic reticulum. They are indicative of accelerated cell maturation or severe inflammation, commonly associated with conditions like bacterial infections, sepsis, burns, and trauma.

Neutrophils and Bacterial Infections
Abnormal Morphological Features
NEUTROPHILS:
Granulation:
- Toxic (increased) granulation
.
Other cytoplasmic inclusions:
- Döhle bodies
- Bacteria (intracellular)
.
Vacuolation (from phagocytosed pathogens):
- Toxic changes
- Bacteria may be present inside vacuole
Neutrophillia with Toxic Granulation
- Secondary to severe bacterial sepsis
- Increased granules, vacuoles, bacteria
.
- on the left we see reactive neutrophillia with left shift. Theres the band form reactive with toxic granulation
- in the middle there are lots of vacuoles (white parts) present in cells that are barely recognisable as being neutrophils. so these are neutrophils that have been out there and removing pathogen, forming these phagocytic vesicles
- on the right is the most severe. weve gone and removed pathogens but we have diplococci present within the phagocytic vesicles. these are in the process of phagocytising


Severe Bacterial Infection: Dohle Bodies
- Basophillic neutrophil cytoplasmic inclusions
- Evidence of long-standing severe bacterial sepsis

Bone Marrow Response
- BM responds by increasing neutrophil production
- Reactive granulocytic hyperplasia with "left shift"
- Increased BM macrophages
.
- there are no fat spaces in this bone marrow this is all granulocytic hyperplasia (increase in granulopoiesis)
- on the right we see cells on aspirate and majority of them are of the granulocytic lineage


Neutropenia
- Neutrophil count <1.5 x 10^9/L
.
Causes:
- Congenital (rare); Benign ethnic neutropenia
- Drug-induced: Antibiotics; cytotoxics
- Infections: Viral or bacterial
- Bone marrow failure (pancytopenia)
.
- Risk of severe & recurrent bacterial infection
- Assoc. with infections of mouth and throat
.
Therapy:
- Treat underlying cause
- Antibiotics: prophylactic for procedures


A neutrophillia may be seen in
- bacterial infection
- pregnancy
- stress

Which of the cells in this image are neutrophils
ONLY 3:
- on the left side middle
- slightly left of the absolute middle
- slightly right to the absolute middle, 3rd one from the top of that associated column


What morphological features can you see in neutrophils
- bacteria


b) Eosinophils
- eosinophils are slightly larger then a neutrophil
- the granules are orange (or eosinophillic)
- one segment of the nucleus and another and these really large granules, much larger then in a neutrophil and more of them

Eosinophils
- Eosinophilic differentiation (specific granules) at the myelocyte stage
.
Morphology:
- Diameter of 12 - 17 micrometres
- Cytoplasm packed with large round granules
- Red-orange with Romanowsky stains
- Nucleus has 2-segments
.
- Circulation time: t1/2 of about 4.5 - 8 hours
- Survive in tissues for 8 - 12 days
- 1 - 5% of leucocytes (0.1-0.4 x10^9/L)
.
- often described as being like glasses with a nose piece


Eosinophil Life Span and Function
- Granule contents: includes histaminase
- Involved in allergy
- Role in regulating immediate type hypersensitivity reactions
- Reactive eosinophilia: allergy, drugs, asthma, dermatitis, parasites
- Malignant (neoplastic): eosinophilic leukaemia

Eosinophillia
Reactive vs Malignant shown
.
- on the left, some eosinophils dont look normal. with treatment they disappear rapidly
- on the right its dificult to differentiate between reacctive and malignant but the way to tell is bald spots present in cytoplasm (some spots devoid of granules).


c) Basophils
DIAGRAM ON SLIDE 29


Basophils
- Most infrequent leucocyte (0.1 x109/L)
- Diameter of about 12 micrometres
- Large round purple-black cytoplasmic granules that overlie nucleus; nucleus has two segments
- Granules: histamine; tryptase
- Role: immune responses to parasites
.
- we use basophils in another way to make diagnosis of chronic myeloid leukaemia. the pointed basophils dont look like normal ones (top right of slide) because they are hypogranular and now we can see the nucleus


An increase in eosinophils can be seen in
Asthma
.
- staph infection causes neutrophillia


A basophilia can be seen in
Chronic Myeloid Leukaemia


d) Monocytes
DIAGRAM ON SLIDE 33

Monocytes
- 2 - 8% of white cells (= 0.2 - 0.8 x10^9/L)
- Maturation from stem cell - monoblast - monocyte
- 20 - 40 hrs in blood
- Mature to macrophage in tissue (months - years)
- Grey cytoplasm; horseshoe-shaped nucleus
- Role in phagocytosis of foreign material & killing
- May have fine granules: produce & release cytokines
.
- the nucleus is not segmented, its just bent
- mature from haemopoietic stem cell
- they mature to marcophage in the tissue (macro = big, phage = eating cell)
- they respond to cytokines (monocyte or macrophage colony stimulating factor) but also release cytokines (which are toxic to what has invaded)
- they are deadly to invaders but they can also be damaging to our own cells if acting in a hyperactive manner


Monocyte Function
Granule contents:
- Enzymes: acid phosphatase, esterases
- Lysozyme, defensins, collagenase
- Coagulation system proteins
.
- Role in phagocytosis and cell killing
.
Monocytosis:
- Chronic infections (e.g. TB)
- Chronic inflammation
- Chronic myelomonocytic leukaemia
.
- reactive monocytosis occurs in response to chronic infections such as tuberculosis or chronic inflammation
- so if a patient who has a persistent increase in monocytes and they look normal and the patient has respiratory distress or a respiratory problem or an abnormality on chest Xray we may suggest testing for Tb


e) Lymphocytes
- second most common white cells in blood
- small round cell produced in bone marrow
- two main subtypes depending on antigen expression: B cells and T cells
- B cells are antibody producing, T cells involved in cell mediated immunity
- also another subtype called natural killer cells (these have granules in cytoplasm which contain enzymes involved in cell killing)


Lymphocytes
- Immunologically competent cells
- Produced in bone marrow and thymus
- BM: 10-15% of BM cells; T : B ratio = 6:1
- 20 - 45% of white cells (= 1.5 - 4 x109/L)
- PB: T (70-85%) and B (5-25%) lymphocytes
- Round cells with mature chromatin
- Some are larger and have cytoplasmic granules

Lymphopoiesis
DIAGRAM ON SLIDE 38


Number and Function of Lymphocytes
- Age-dependent reference ranges
- Average life span 4 years (up to 10 years)
.
Two major functionally distinct groups, B- and T-cells
- PB: T (70-85%) and B (5-25%) lymphocytes
- Also natural killer cells (large granular lymphocytes <5%)
.
- T cells: Cell mediated immunity
.
B cells:
- Produce immunoglobulins (groups of proteins)
- Further development of B lymphocytes in lymph nodes

Age and Lymphocytes
DIAGRAM ON SLIDE 40


Lymphocytosis
Reactive: most commonly secondary to viral infections
- Lymphocytes react to the infection
- Infectious mononucleosis (EBV; glandular fever)
- Also: CMV, COVID-19, viral hepatitis, Varicella
- Altered morphology: increased size and cytoplasm
.
- Can occur secondary to bacterial infection: e.g. B. pertussis; whooping cough) in children
.
Lymphocytosis due to malignancies:
- Acute and chronic leukaemias
- Lymphoma

Lymphocytosis (Reactive vs Malignant)
DIAGRAM ON SLIDE 42

Infectious Mononucleosis
- Epstein-Barr virus (EBV)
- Teenagers and young adults
- Lassitude, fever, pharyngitis, lymphadenopathy, hepatosplenomegaly
.
Blood film: virally infected B lymphocytes and activated reactive T lymphocytes (CD8-positive)
- Thrombocytopenia is common
- Haemolytic anaemia (immune-mediated; spherocytes)

Infectious Mononucleosis (EBV)
- large activated lymphocytes with irregularly shaped nuclei; abundant flowing basophilic cytoplasm with a dark-staining periphery

Cytomegalovirus (CMV)
- Similar clinical features to EBV
- Pharyngitis and lymphadenopathy: rare
- Ages 20 - 50 years
- Virus infects the neutrophils, which spread the infection to the macrophages
- Indistinguishable from EBV cells
- Reactive T lymphocytes in the blood
.
- in CMV its generally of the neutrophils and then its a lymphocytic response


An increase in lymphocytes can be seen in
Viral infections


Common morphological features of activated lymphocytes include (2 answers)
- large cell size and cytoplasmic basophillia
.
- baso means blue on staining (look on slide 44)
- its like the cell wall is trying to spread beyond its confines but weve got a ruffing up because theres too much cytoplasm and it gives basophillia


Bone Marrow Failure
- Inability of BM to produce sufficient blood cells
- Leads to "pancytopenia"
.
Clinical features:
- Symptoms and signs of anaemia, bleeding, infections


Causes of Bone Marrow Failure
DIAGRAM ON SLIDE 49


Aplastic Anaemia
- Pancytopenia due to bone marrow failure
- Hypoplastic or aplastic bone marrow
.
Cause:
- Congenital: Fanconi anaemia
- Acquired: Idiopathic, Chemotherapy, Chemicals/toxins, Infections
.
- a means without
- plasia means to make
- bone marrow should be red, but the diagram shows its full of fat (making it yellow). it should be full of cells. this is clearly the bone marrow of someone whos deceased

Aplastic Anaemia Clinical Features
- Any age; 2-5 / million
- Generally rapid onset
Aplastic Anaemia Laboratory Features
- Pancytopenia: normocytic anaemia; neuts <1; plt <10
- BM: >75% fat spaces; few haemopoietic cells
Aplastic Anaemia Treatment
- Immune suppression and blood products
- Haemopoietic growth factors
- May require bone marrow transplantation

Bone marrow failure leads to
Reduced erythropoiesis, reduced granulopoiesis and reduced megakaryopoiesis


Learning Outcomes
DIAGRAM ON SLIDE 53
